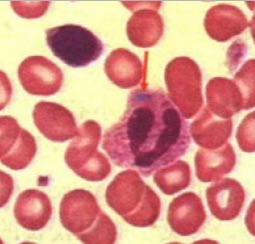

benshenmed(官方) 2020年08月20日
形态学 185
杜勒小体又称Dohle小体: 中性粒细胞因毒性变化而在胞质中保留的局部嗜碱性区域(源自RNA),呈圆形、梨形或云雾状,染成天蓝色或灰蓝色,直径0. 1~2um,最大可达5um,单个或多个,常位于细胞边缘,超微结构显示,为粗面内质网组成,与正常染色区域界限模糊,是胞质局部不成熟即核质发育不平衡的表现。常见于严重感染,如肺炎、麻疹、败血症和烧伤等。

全屏 最小
benshenmed(官方) 2020年08月20日
形态学 185
杜勒小体又称Dohle小体: 中性粒细胞因毒性变化而在胞质中保留的局部嗜碱性区域(源自RNA),呈圆形、梨形或云雾状,染成天蓝色或灰蓝色,直径0. 1~2um,最大可达5um,单个或多个,常位于细胞边缘,超微结构显示,为粗面内质网组成,与正常染色区域界限模糊,是胞质局部不成熟即核质发育不平衡的表现。常见于严重感染,如肺炎、麻疹、败血症和烧伤等。
全屏 最小
检验速记关闭
APP下载